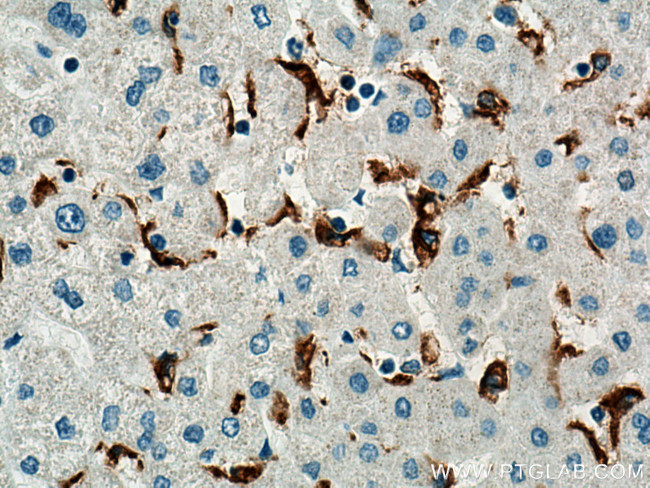
MSR1 Antibody in Immunohistochemistry (Paraffin) (IHC (P))

Search
Proteintech
MSR1 Polyclonal Antibody
{{$productOrderCtrl.translations['antibody.pdp.commerceCard.promotion.promotions']}}
{{$productOrderCtrl.translations['antibody.pdp.commerceCard.promotion.viewpromo']}}
{{$productOrderCtrl.translations['antibody.pdp.commerceCard.promotion.promocode']}}: {{promo.promoCode}} {{promo.promoTitle}} {{promo.promoDescription}}. {{$productOrderCtrl.translations['antibody.pdp.commerceCard.promotion.learnmore']}}
产品信息
17858-1-AP
种属反应
宿主/亚型
分类
类型
抗原
偶联物
形式
浓度
规格
纯化类型
保存液
内含物
保存条件
运输条件
产品详细信息
Aliquoting is unnecessary for -20°C storage.
靶标信息
CD204 gene encodes the class A macrophage scavenger receptors, which include three different types (1, 2, 3) generated by alternative splicing of this gene. These receptors or isoforms are macrophage-specific trimeric integral membrane glycoproteins and have been implicated in many macrophage-associated physiological and pathological processes including atherosclerosis, Alzheimer's disease, and host defense. The isoforms type 1 and type 2 are functional receptors and are able to mediate the endocytosis of modified low density lipoproteins (LDLs). The isoform type 3 does not internalize modified LDL (acetyl-LDL) despite having the domain shown to mediate this function in the types 1 and 2 isoforms. It has an altered intracellular processing and is trapped within the endoplasmic reticulum, making it unable to perform endocytosis. The isoform type 3 can inhibit the function of isoforms type 1 and type 2 when co-expressed, indicating a dominant negative effect and suggesting a mechanism for regulation of scavenger receptor activity in macrophages. Diseases associated with MSR1 include Barrett Esophagus and Prostate Cancer.
仅用于科研。不用于诊断过程。未经明确授权不得转售。
生物信息学
蛋白别名: CD204; Macrophage acetylated LDL receptor I and II; macrophage scavenger receptor type III; Macrophage scavenger receptor types I and II; Scavenger receptor class A member 1; SR-AI/II; unnamed protein product
基因别名: CD204; MSR1; phSR1; phSR2; SCARA1; SR-A; SR-AI; SR-AII; SR-AIII; SRA
UniProt ID: (Human) P21757
Entrez Gene ID: (Human) 4481